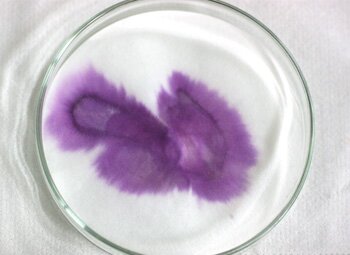

鑑定内容 |
【精液判定】
物品・(衣服や物)に付着した物体が、精液か否かを判定いたします

付着物がヒトに由来する精液か否か
そして、付着物がヒト精液と判定された場合
法医学検査=血液型、DNA鑑定により個人識別も可能になります。
この、ヒトの精液に由来する物質なのか否かを
判定することを「精液判定」と呼びます
![]()
【精液の証明】
性的犯罪の証明として重要なのは精液(精子)の検出です。
精液とは、動物の睾丸・精嚢線・前立腺などからの分泌物が混合したもので、
その主成分は、睾丸から作られる精子と前立腺分泌物でです。
ヒトの精液(精子)は、乾燥したものは無臭ですが、新鮮なものは特有の臭気を有し、
布地などに付着すると地図上に広がり、淡黄色~灰色の混濁した粘稠液です。
精液の証明は、生化学的検査→生物学的検査を経て
総合的な判定により証明が行われます。
以下にて、代表的な検査法をご紹介いたします。
![]()
【①-外観検査】
精液の外観特徴は、衣類や紙片に付着すると、淡黄色を帯びた灰色の斑痕となり、
そのタンパク質成分によりごわごわした硬さがあります。
![]()
【②-光学検査法】
外観検査後、紫外線領域を利用したALS検査を行います。
暗室内において資料にALS光源照射を行うと精液特有の蛍光が観察されます。

現在では、この光学検出試験が精液の重要な証明方法と位置づけられています。
![]()
【③-顕微鏡検査】
精子の詳細と同定のために、染色を施し検査を行います。
染色された精子の形態学的評価を行い、間違いなく精子か否かを判定します。
染色には、バエッキー染色、コランストッキー染色
パパニコロウ染色法・ショール染色法・Diff-Quik染色法などを用い
光学顕微鏡検査を行います。

パパニコロウ染色は、細胞診断のために開発された病理検査法で、
子宮癌や肺癌の検診にも取り入られている検査法です。
パパニコロウ染色は核染色と細胞質染色があり、この染色法で精子を染色します。
頭部の先端は淡い青色に染まり、中片部は赤く染まり、後部は暗い青に染まります。
ショール染色は膣スメアにおけるホルモン動態の評価を目的として開発された染色法です。
染色法が簡易な事からパパニコロウ染色の代わりに敏速細胞診断に用いられています。
Diff-Quik染色法は、湿固定によるパパニコロウ染色で細胞の剥離が多い
液状検体に対して細胞保有率が高い標本作成法とされ、
パパニコロウ染色よりも敏速な細胞診断が必要な場合に用いられている染色法です。
染色法は数多く存在し日夜進化を続けています。
さまざまな状態の試料を扱う法科学分野では、
試料状態により検証済みの染色法を使い分けます。
その試料状態に対して臨機応変に対応し、その答えを導くのが使命だからです。
![]()
【④-化学的検査】
事件資料などでは、精液の付着した箇所は、事件の真相を探る重要な証拠となります。
この化学的検査は、精液の付着箇所を特定する目的で使用される方法です。
前立腺由来の酵素である酸性フォスターゼの活性を利用して
試薬を発色させ、精液付着部位を探査します。
外観検査やALS検査で精液の付着部位が分からない資料や
非常に薄い精液斑痕などの場合でも、精液の付着部位を探査する事が出来ます。
酸性フォスファターゼの持つ燐酸エステルを加水分解する機能を応用した解析方法です。
一般的には「SM試薬」と呼ばれるものが用いられています。
![]()
【⑤-血清学的検査】
ヒトの精液が付着しているかどうかについて、
抗ヒト精液沈酵素および抗ヒト血清タンパク質沈酵素を用いた検査が行われます。
また、免疫クロマト法を応用した、前立腺肥大・前立腺癌のスクリーニング用
検査試薬も高感度な検査法と知られています。
さらに、精漿に含まれる前立腺特異抗原(SPA)というタンパク質を
検査する方法もあります。
![]()
【⑥-解析】
各種の検査結果を分析し、
総合的にヒトの精液(精子)か否かの解析が行われます。
精液判定の評価は、その『物に対する知識』よりも
その『物を見極める為の技術』が重要な鑑定と言えるのです。
![]()
|精液判定 |精液からの個人識別① |精液からの個人識別② |よくあるトラブル |精液判定の費用|
![]()
【科学捜査読本@法科研・絶賛発売中!】
![]() |
『科学捜査』 あの事件の犯人は、 これで浮かび上がった! (主婦の友ベストBOOKS) 主婦の友:刊 法科学鑑定研究所 定価:1575円 ISBN978-4-07-273838-2 |
![]() |
『犯人は知らない 科学捜査の最前線』 (ナレッジエンタ読本) メディアファクトリー:刊 法科学鑑定研究所 定価:945円(税込) ISBN:978-4-8401-3033-2 |


